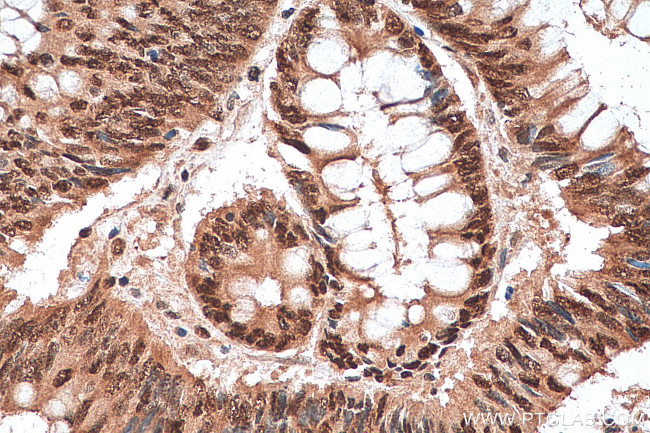
TAF15 Antibody in Immunohistochemistry (Paraffin) (IHC (P))
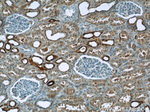
TAF15 Antibody in Immunohistochemistry (Paraffin) (IHC (P))

Search
Proteintech
TAF15 Polyclonal Antibody
{{$productOrderCtrl.translations['antibody.pdp.commerceCard.promotion.promotions']}}
{{$productOrderCtrl.translations['antibody.pdp.commerceCard.promotion.viewpromo']}}
{{$productOrderCtrl.translations['antibody.pdp.commerceCard.promotion.promocode']}}: {{promo.promoCode}} {{promo.promoTitle}} {{promo.promoDescription}}. {{$productOrderCtrl.translations['antibody.pdp.commerceCard.promotion.learnmore']}}
产品信息
25521-1-AP
种属反应
宿主/亚型
分类
类型
抗原
偶联物
形式
浓度
规格
纯化类型
保存液
内含物
保存条件
运输条件
靶标信息
Initiation of transcription by RNA polymerase II requires the activities of more than 70 polypeptides. The protein that coordinates these activities is transcription factor IID (TFIID), which binds to the core promoter to position the polymerase properly, serves as the scaffold for assembly of the remainder of the transcription complex, and acts as a channel for regulatory signals.
仅用于科研。不用于诊断过程。未经明确授权不得转售。
篇参考文献 (0)
生物信息学
蛋白别名: 68 kDa TATA-binding protein-associated factor; hTAFII68; RBP56/CSMF fusion; RNA-binding protein 56; TAF(II)68; TAF15 RNA polymerase II, TATA box binding protein (TBP)-associated factor, 68 kDa; TAF15 RNA polymerase II, TATA box binding protein (TBP)-associated factor, 68kDa; TATA box binding protein (TBP)-associated factor, RNA polymerase II, N, 68kD (RNA binding protein 56); TATA box binding protein (TBP)-associated factor, RNA polymerase II, N, 68kD (RNA-binding protein 56); TATA box-binding protein-associated factor 2N (RNA-binding protein 56); TATA-bin; TATA-binding protein-associated factor 2N; TBP-associated factor 15; unnamed protein product
基因别名: 2610111C21Rik; 68kDa; Npl3; RBP56; TAF15; TAF2N; TAFII68
UniProt ID: (Human) Q92804
Entrez Gene ID: (Human) 8148, (Mouse) 70439